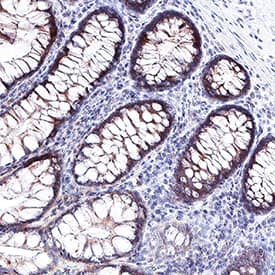
Galectin-9 antibody in Human Colon by Immunohistochemistry (IHC-P).

Human Galectin-9 Antibody
R&D Systems, part of Bio-Techne | Catalog # MAB20455


Key Product Details
Validated by
Species Reactivity
Applications
Label
Antibody Source
Product Specifications
Immunogen
Ala2-Thr323
Accession # O00182
Specificity
Clonality
Host
Isotype
Scientific Data Images for Human Galectin-9 Antibody
Detection of Human Galectin‑9 by Western Blot.
Western blot shows lysates of HEK293 human embryonic kidney cell line either mock transfected or transfected with human Galectin-9 . PVDF membrane was probed with 2 µg/mL of Mouse Anti-Human Galectin-9 Monoclonal Antibody (Catalog # MAB20455) followed by HRP-conjugated Anti-Mouse IgG Secondary Antibody (Catalog # HAF018). A specific band was detected for Galectin-9 at approximately 45 kDa (as indicated). This experiment was conducted under reducing conditions and using Immunoblot Buffer Group 1.Detection of Galectin-9 in Human PBMCs by Flow Cytometry.
Human peripheral blood mononuclear cells (PBMCs) either (A) treated with 5 ng/mL PHA for 2 days or (B) untreated, were stained with Mouse Anti-Human Galectin-9 Monoclonal Antibody (Catalog # MAB20455) followed by Allophycocyanin-conjugated Anti-Mouse IgG Secondary Antibody (Catalog # F0101B) and Mouse Anti-Human CD3 epsilon PE-conjugated Monoclonal Antibody (Catalog # FAB100P). Quadrant markers were set based on control antibody staining (Catalog # MAB003). View our protocol for Staining Membrane-associated Proteins.Galectin‑9 in Human Colon.
Galectin-9 was detected in immersion fixed paraffin-embedded sections of human colon using Mouse Anti-Human Galectin-9 Monoclonal Antibody (Catalog # MAB20455) at 0.5 µg/mL for 1 hour at room temperature followed by incubation with the Anti-Mouse IgG VisUCyte™ HRP Polymer Antibody (Catalog # VC001). Before incubation with the primary antibody, tissue was subjected to heat-induced epitope retrieval using Antigen Retrieval Reagent-Basic (Catalog # CTS013). Tissue was stained using DAB (brown) and counterstained with hematoxylin (blue). Specific staining was localized to bile canaliculi. View our protocol for IHC Staining with VisUCyte HRP Polymer Detection Reagents.Applications for Human Galectin-9 Antibody
CyTOF-ready
Flow Cytometry
Sample: Human PBMC treated with PHA
Immunohistochemistry
Sample: Immersion fixed paraffin-embedded sections of human colon
Western Blot
Sample: HEK293 human embryonic kidney cell line either mock transfected or transfected with human Galectin‑9
Formulation, Preparation, and Storage
Purification
Reconstitution
Formulation
Shipping
Stability & Storage
- 12 months from date of receipt, -20 to -70 °C as supplied.
- 1 month, 2 to 8 °C under sterile conditions after reconstitution.
- 6 months, -20 to -70 °C under sterile conditions after reconstitution.
Background: Galectin-9
Galectins comprise a family of multifunctional carbohydrate-binding proteins with specificity for N‑acetyl-lactosamine-containing glycoproteins. At least 14 mammalian Galectins share structural similarities in their carbohydrate recognition domains (CRD), forming three groups: prototype (one CRD), tandem-repeat (two CRDs), and chimeric (one CRD, unique N‑terminus) (1, 2). Full length Galectin-9 is a widely expressed 39 kDa tandem-repeat Galectin that contains two CRDs connected by a linker region (3). Progressive deletion within the linker region generates a 36 kDa isoform, also known as Ecalectin or UAT, as well as a 35 kDa isoform (4). This recombinant protein corresponds to the Ecalectin isoform of human Galectin-9 and shares 70% and 73% aa sequence identity with the corresponding regions of mouse and rat Galectin-9, respectively. Galectin-9 exhibits a wide range of activities. All three isoforms function as eosinophil chemoattractants (5, 6). This activity is destroyed by thrombin-mediated cleavage within the linker region of the long isoform, although the Ecalectin isoform is resistant to thrombin (7). Galectin-9 binds to carbohydrate moieties of IgE, thereby preventing immune complex formation, mast cell degranulation, and asthmatic and cutaneous anaphylaxis reactions (8). Independent of its lectin properties, Galectin-9 induces the maturation of dendritic cells which promote Th1 polarization (9). Galectin-9 induces cellular apoptosis in part by direct binding to TIM-3 (10, 11). Its interaction with TIM-3 inhibits Th1 cell and CD8+ cytotoxic T cell responses and also promotes regulatory T cell differentiation and activity (11, 12). Galectin-9 suppresses tumor cell metastasis by interfering with the associations between hyaluronic acid and CD44 and between VCAM-1 and Integrin alpha4 beta1 (13). The Ecalectin isoform (UAT; urate transporter) can also be expressed as an integral membrane protein and mediate the cellular efflux of urate (14).
References
- Yang, R-Y. et al. (2008) Expert Rev. Mol. Med. 10:e17.
- Elola, M. T. et al. (2007) Cell. Mol. Life Sci. 64:1679.
- Tureci, O. et al. (1997) J. Biol. Chem. 272:6416.
- Chabot, S. et al. (2002) Glycobiology 12:111.
- Matsumoto, R. et al. (2002) J. Immunol. 168:1961.
- Sato, M. et al. (2002) Glycobiology 12:191.
- Nishi, N. et al. (2006) Glycobiology 16:15C.
- Niki, T. et al. (2009) J. Biol. Chem. 284:32344.
- Dai, S.-Y. et al. (2005) J. Immunol. 175:2974.
- Seki, M. et al. (2007) Arthritis Rheum. 56:3968.
- Zhu, C. et al. (2005) Nat. Immunol. 6:1245.
- Sehrawat, S. et al. (2010) PloS Pathogens 6:e1000882.
- Nobumoto, A. et al. (2008) Glycobiology 18:735.
- Leal-Pinto, E. et al. (2002) Am. J. Physiol. Renal Physiol. 283:F150.
Alternate Names
Gene Symbol
UniProt
Additional Galectin-9 Products
Product Documents for Human Galectin-9 Antibody
Product Specific Notices for Human Galectin-9 Antibody
For research use only